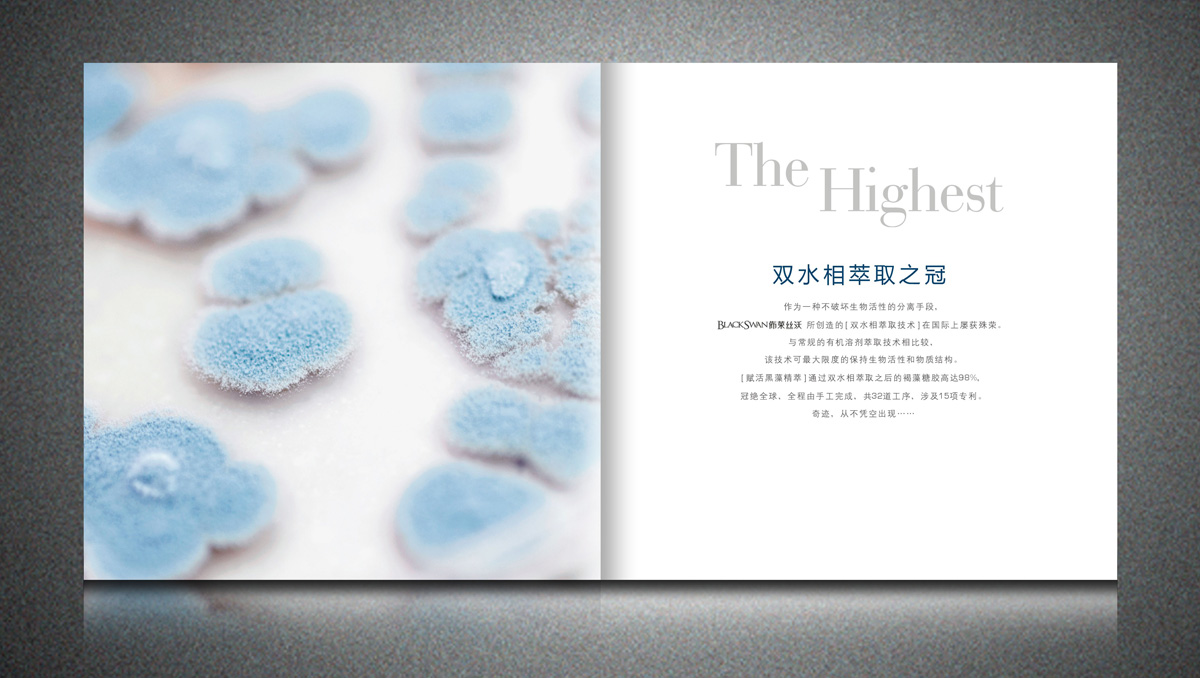

客戶:美肌精萃優白系畫冊
案例標簽:畫冊設計
項目背景
美肌化妝品有限公司是一家集容化妝品研發、生產、銷售、服務為一體的大型現代化企業。以傳統中醫理論、現代醫學、基因生物工程、美容最新研究成果和全新的產品設計理念為客戶提供高價值的服務。 ? ? ? 美肌——真正的純天然活性成分,新鮮的野生、有機植物為原料,三大國際尖端技術支持。國際專家級的研發隊伍,環保包裝、鮮活設計、安全健康、無添加——肌膚保鮮的秘密! ? ? ? “美肌”是專為現代女性設計的生態型護膚品牌,全新高效的肌膚護理保養方式,秉承“女人之美源自天然”的理念,倡導天然、綠色、健康的“生生態養顏”之道,每一款產品都來自于自然的植物精粹,糅合國際尖端的生物科技,帶來了超乎想象的肌膚問題解決方案,使肌膚盡享天然、高效、溫和無刺激的呵護。 東炫設計-廣州品牌設計公司,專注于畫冊設計,食品包裝設計,化妝品包裝設計,標志設計,VI設計。